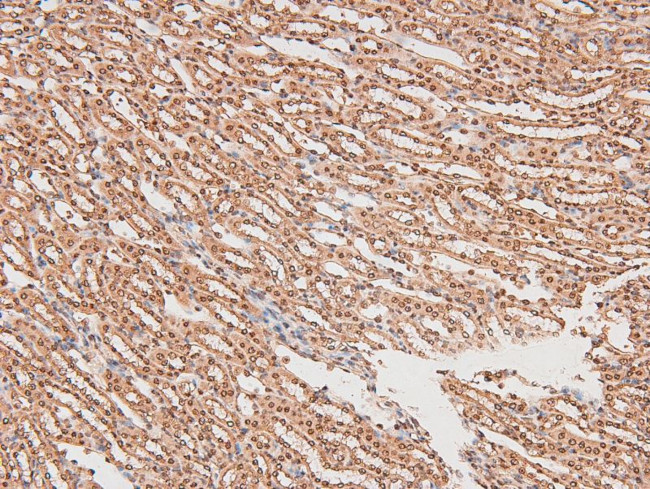
Phospho-FGR (Tyr412) Antibody in Immunohistochemistry (Paraffin) (IHC (P))

Search
Invitrogen
Phospho-FGR (Tyr412) Polyclonal Antibody
{{$productOrderCtrl.translations['antibody.pdp.commerceCard.promotion.promotions']}}
{{$productOrderCtrl.translations['antibody.pdp.commerceCard.promotion.viewpromo']}}
{{$productOrderCtrl.translations['antibody.pdp.commerceCard.promotion.promocode']}}: {{promo.promoCode}} {{promo.promoTitle}} {{promo.promoDescription}}. {{$productOrderCtrl.translations['antibody.pdp.commerceCard.promotion.learnmore']}}
图: 1 / 5
Phospho-FGR (Tyr412) Antibody (PA5-105883) in IHC (P)





Please note: We are reviewing Western blot images included in the antibody testing data in our catalog, including those provided by third parties. Unless expressly labeled or annotated as “raw-unedited”, Western blot images included in the antibody testing data in our catalog may have been edited, optimized or otherwise adjusted for presentation.
产品信息
PA5-105883
种属反应
宿主/亚型
分类
类型
抗原
偶联物
形式
浓度
规格
纯化类型
保存液
内含物
保存条件
运输条件
RRID
产品详细信息
Antibody detects endogenous levels of FGR only when phosphorylated at Tyr412.
靶标信息
FGR is a SRC-related kinase present in hematopoietic cells. FGR signals within multiple pathways including within the integrin pathway and downstream of chemokine and cytokine receptors. This protein contains N-terminal sites for myristylation and palmitoylation, a PTK domain, and SH2 and SH3 domains which are involved in mediating protein-protein interactions with phosphotyrosine-containing and proline-rich motifs, respectively. It localizes to plasma membrane ruffles, and functions as a negative regulator of cell migration and adhesion triggered by the beta-2 integrin signal transduction pathway. Infection with Epstein-Barr virus results in the overexpression of this protein.
仅用于科研。不用于诊断过程。未经明确授权不得转售。
生物信息学
蛋白别名: EC 2.7.10.2; feline Gardner-Rasheed sarcoma viral oncogene; FGR protein; FLJ43153; Gardner-Rasheed feline sarcoma viral (Fgr) oncogene homolog; Gardner-Rasheed feline sarcoma viral (v-fgr) oncogene homolog; MGC75096; OTTHUMP00000003603; OTTHUMP00000003604; p55-Fgr; p58-Fgr; p58c-Fgr; Proto-oncogene c-Fgr; proto-oncogene tyrosine-protein kinase Fgr; Tyrosine-protein kinase Fgr
基因别名: FGR; p55-Fgr; SRC2
UniProt ID: (Mouse) P14234, (Rat) Q6P6U0
Entrez Gene ID: (Mouse) 14191, (Rat) 79113